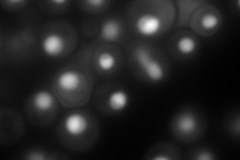
YDR035W
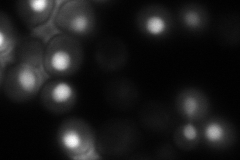
YDR035W
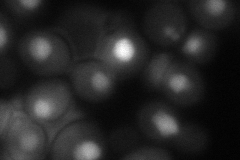
YDR035W
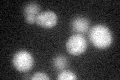
YDR035W

View description
3-deoxy-D-arabino-heptulosonate-7-phosphate (DAHP) synthase, catalyzes the first step in aromatic amino acid biosynthesis and is feedback-inhibited by phenylalanine or high concentration of tyrosine or tryptophan
Localization:
Intensity:
Fold change:
Significance:
-
C’ GFP library in SD

below threshold17.98 -
N' NOP1pr-GFP in SD
nucleus342.623 -
N' TEF2pr-mCherry in SD

nucleus385.878 -
N' NATIVEpr-GFP in SD
nucleus158.298 -
N' TEF2pr-VC and Cyto-VN in SD
nucleus86.9946 -
C’ GFP library in SD+DTT
cytosol15.480.86No -
C’ GFP library in SD+H2O2

cytosol18.021No -
C’ GFP library in Starvation Media

cytosol24.781.37No -
C’ GFP library on the background of Pup2-DaMP

below threshold -
C’ GFP library on the background of CCT mutant

below threshold16.85560.936852No
